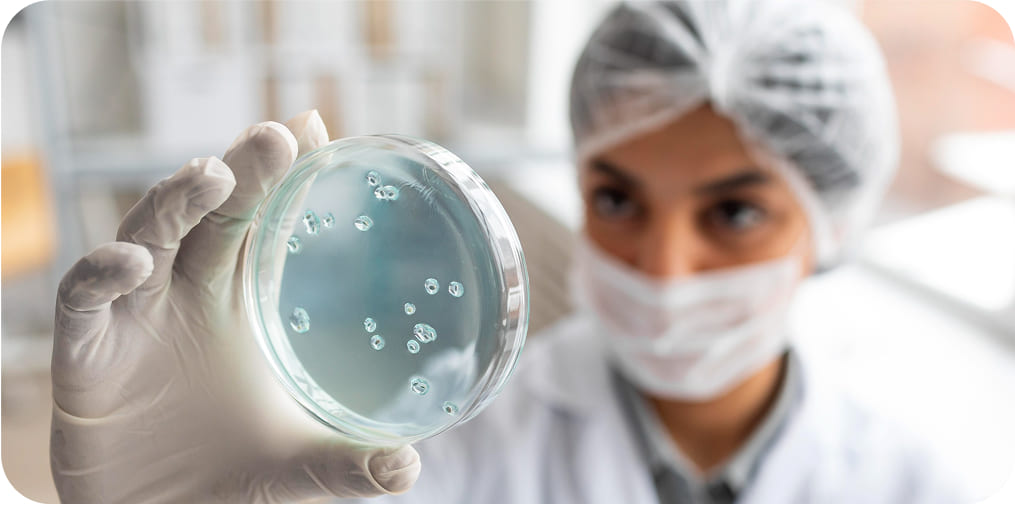

Explore our upcoming events and see what’s next in compliance and digital solutions.
The PAM module provides real-time monitoring capabilities through intuitive dashboards, offering immediate visibility into the status of all approved protocols. It ensures thorough oversight by tracking activities and findings across protocols, helping you stay compliant at all times. Additionally, it maintains detailed audit trails for easy access during regulatory inspections.
The PAM module simplifies the process of submitting amendment protocols by automating the workflow. When monitoring findings highlight necessary changes, it enables investigators to quickly and accurately submit the required amendments to address compliance issues, ensuring that any adjustments are properly documented and promptly addressed.
PAM maintains comprehensive monitoring documentation and audit trails, ensuring that all protocol activities are well-documented and easily accessible during regulatory inspections. This eliminates the risk of missing key compliance records and ensures you're always inspection-ready.
For smaller teams or independent research institutions, PAM simplifies post-approval monitoring workflows by automating routine tasks, tracking findings, and sending reminders. This helps reduce the administrative burden, allowing smaller teams to focus on high-priority research tasks while ensuring compliance with relevant regulations.
The PAM module enhances team productivity by automating monitoring tasks, ensuring that inspection teams are assigned to the right protocols at the right time. It also facilitates cross-departmental collaboration by providing centralized oversight and improving coordination, especially in large institutions such as universities or multi-site research organizations.
PAM supports compliance with global regulatory requirements by ensuring that all monitoring activities align with guidelines from organizations such as the FDA, EMA, and ICH. It helps track activities, findings, and corrective actions that meet these standards, safeguarding your research against regulatory risks.
The PAM module integrates seamlessly with your existing IRB, IACUC, and other research compliance modules, ensuring a unified, end-to-end monitoring system. This integration enables comprehensive oversight of all research protocols, facilitating easier tracking of findings, management of corrective actions, and ensuring compliance throughout the entire research lifecycle.